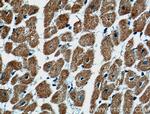
ARHGAP10 Antibody in Immunohistochemistry (Paraffin) (IHC (P))

Search
Proteintech
ARHGAP10 Polyclonal Antibody
{{$productOrderCtrl.translations['antibody.pdp.commerceCard.promotion.promotions']}}
{{$productOrderCtrl.translations['antibody.pdp.commerceCard.promotion.viewpromo']}}
{{$productOrderCtrl.translations['antibody.pdp.commerceCard.promotion.promocode']}}: {{promo.promoCode}} {{promo.promoTitle}} {{promo.promoDescription}}. {{$productOrderCtrl.translations['antibody.pdp.commerceCard.promotion.learnmore']}}
产品信息
55139-1-AP
种属反应
已发表种属
宿主/亚型
分类
类型
抗原
偶联物
形式
浓度
规格
纯化类型
保存液
内含物
保存条件
运输条件
产品详细信息
The antibody is specific to ARHGAP10.
靶标信息
GTPase activator for the small GTPases RhoA and Cdc42 by converting them to an inactive GDP-bound state. Essential for PTKB2 regulation of cytoskeletal organization via Rho family GTPases. Inhibits PAK2 proteolytic fragment PAK-2p34 kinase activity and changes its localization from the nucleus to the perinuclear region. Stabilizes PAK-2p34 thereby increasing stimulation of cell death.
仅用于科研。不用于诊断过程。未经明确授权不得转售。
生物信息学
蛋白别名: FLJ20896; Graf-related protein 2; GRAF2; GTPase regulator associated with focal adhesion kinase 2; PH and SH3 domain-containing rhoGAP protein; PS-GAP; PSGAP; Rho GTPase-activating protein 10; Rho-type GTPase-activating protein 10; unnamed protein product
基因别名: A930033B01Rik; ARHGAP10; GRAF2; PS-GAP; PSGAP; PSGAP-m; PSGAP-s
UniProt ID: (Human) A1A4S6, (Mouse) Q6Y5D8
Entrez Gene ID: (Human) 79658, (Mouse) 78514